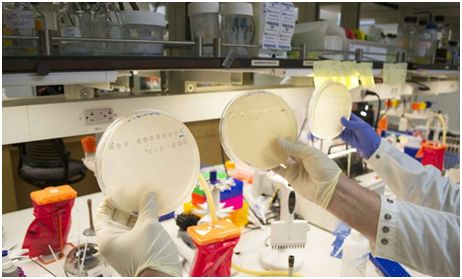

Science:揭示病毒的一种新的进化之路
病毒通过将它们自身结合到细胞表面上的分子受体而感染细胞。这些受体是病毒入侵细胞必须要打开的“锁”。针对这些锁的“钥匙”是被称作宿主识别蛋白的病毒蛋白。在这个领域开展研究的研究人员专注于突变如何改变这些蛋白钥匙以及哪些改变让它们能够打开新的锁。多年来科学家们已知道病毒能够相对较少的突变获得新钥匙,但是他们尚未解决这些突变首次出现的奥秘。这个问题导致与美国加州大学圣地亚哥分校、耶鲁大学和日本东京工业大学的研究人员合作开展研究。
在一项新的研究中,在加州大学圣地亚哥分校生物科学助理教授Justin Meyer和Meyer实验室的Katherine Petri的领导下,这些研究人员利用λ噬菌体开展一系列实验,其中λ噬菌体是一种感染细菌但不感染人体的病毒,从而允许在实验室测试中具有广泛的灵活性。这些研究人员发现λ噬菌体能够像预期的那样感染“正常的”细菌宿主,但是通过一种之前在进化中未观察到的过程获得感染新的宿主靶标的能力。他们说,他们的发现解决了长期存在的关于基因如何获得新功能和突变如何产生从而使得更容易在宿主间传播的秘密,而且可能适用于对寨卡(由寨卡病毒感染导致的)、埃博拉(由埃博拉病毒感染导致的)和禽流感(由禽流感病毒感染导致的)等病毒性疾病的研究。相关研究结果发表在2018年3月30日的Science期刊上,论文标题为“Destabilizing mutations encode nongenetic variation that drives evolutionary innovation”。
图片来自UC San Diego。
Meyer 说,“这项研究表明病毒具有的适应性比之前预期的更强。通过了解病毒如何实现进化灵活性,我们对如何阻止新疾病出现有了新的认识。”
这些研究人员发现通过违反公认的将遗传信息转化为蛋白的分子生物学规则,λ噬菌体克服了使用新受体的挑战。他们发现单一基因(即λ噬菌体宿主识别基因J)有时会产生多种不同的蛋白。这种病毒进化出一种易于出现结构不稳定性的蛋白序列(即宿主识别蛋白J),从而导致至少两种不同的宿主识别蛋白产生。对这种病毒而不是宿主幸运的是,这些不同类型的蛋白能够利用不同的锁。
Petrie说,“我们能够捕获到这个进化过程发挥作用。我们发现这种蛋白存在的‘错误’使得这种病毒感染它的正常宿主和不同的宿主细胞。这种蛋白存在的这种非遗传性变异(nongenetic variation)是一种让单个DNA基因序列获得多种功能的方法。对这种蛋白而言,这就像买一送一。”
(文章来源生物谷)
上一篇:帕金森病的病因也许压根不在大脑里?
下一篇:科学家找到我们记忆力随年龄增大而下降的关键原因!...